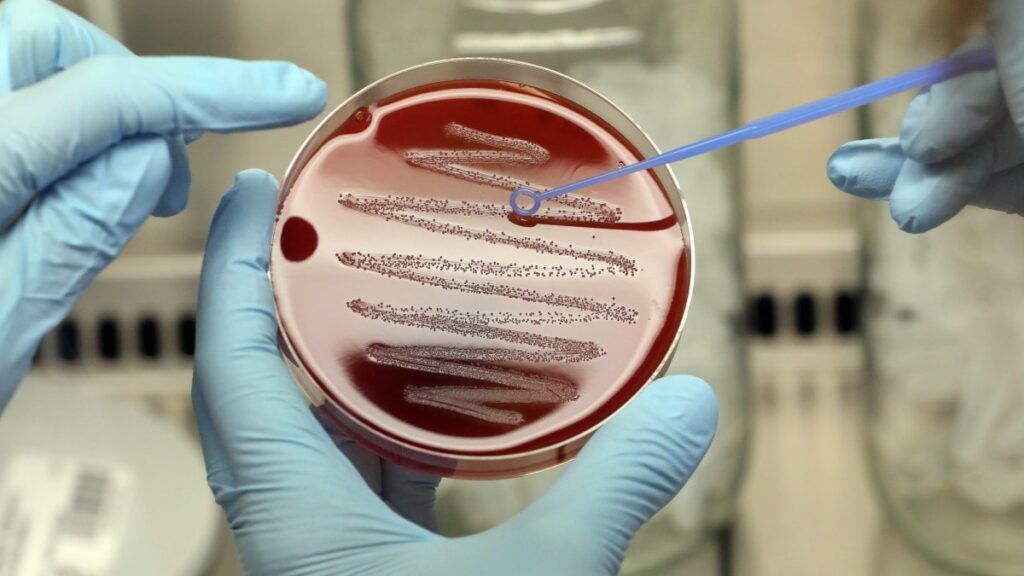
Hospitales reportan aumento de infecciones por estreptococo A en niños

Varios hospitales infantiles en Estados Unidos han detectado aumentos en las infecciones invasivas por estreptococos del grupo A, una enfermedad grave y, a veces, potencialmente mortal que ocurre cuando las bacterias se propagan a áreas del cuerpo que normalmente están libres de gérmenes, como el torrente sanguíneo.
Los hospitales infantiles en Arizona, Colorado, Texas y Washington le dijeron a NBC News que están viendo un número de casos superior al promedio esta temporada en comparación con años anteriores. El Dr. James Versalovic, patólogo en jefe del Texas Children’s Hospital en Houston, dijo que su centro, el hospital pediátrico más grande de EEUU., ha visto “un aumento de más del cuádruple” en infecciones potencialmente invasivas en los últimos dos meses en comparación con el mismo período del año pasado.
Mientras tanto, los Centros para el Control y la Prevención de Enfermedades (CDC, pos sus siglas en inglés) dijeron que están “escuchando anécdotas de algunos médicos estadounidenses sobre un posible aumento en las infecciones [por estreptococo invasivo del grupo A] entre niños en los Estados Unidos” y están “hablando con sitios de vigilancia y hospitales en múltiples estados para aprender más.”
Para más información, visita NBCNews.com